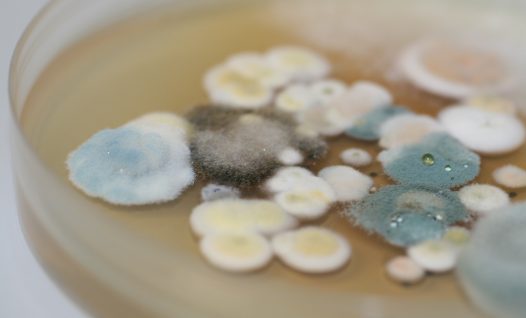

Tagame teile põhjaliku abi seeneprobleemide ennetamisel ja lahendamisel!
Sihtasutuse Eesti Mükoloogiauuringute Keskus visiooniks on olla ehitiste biokahjustuste uurimise eestvedajaks Eestis
Sihtasutus Eesti Mükoloogiauuringute Keskus asutati 2002. aastal. Me aitame kõiki, kellel on hoonetes probleeme biokahjustustega (näiteks hallitusseened, puitulagundavad seened sh majavamm, puitu kahjustavad putukad). Meilt on abi saanud üle 5000 kliendi. Meie meeskonda kuuluvad ehitiste biokahjustuste ja hoonete sisekliima valdkonna ekspert Kalle Pilt, kes saab anda nõu ehituslikes küsimustes ja mükoloog Ave Sadam, kes on spetsialiseerunud hoonetes levivatele seentele.